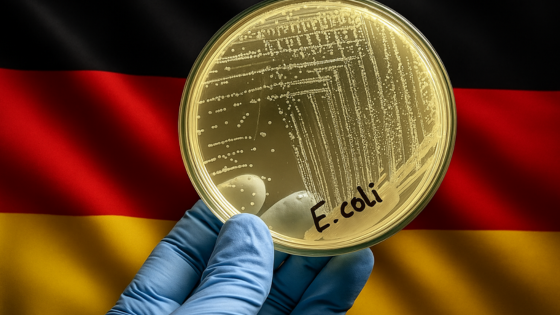

W 2024 roku Belgia odnotowała wzrost liczby ognisk chorób przenoszonych przez żywność oraz związanych z nimi zachorowań i zgonów. Najnowszy raport Federalnej Agencji ds. Bezpieczeństwa Łańcucha Żywności (FASFC) ujawnia nie tylko szczegółowe dane epidemiologiczne, ale także wyniki kontroli, działań prewencyjnych i przypadków oszustw w sektorze spożywczym.
Ognisko zakażeń E. coli w Niemczech: rosnąca liczba ciężkich przypadków
Aktualna sytuacja epidemiologiczna
W północnych Niemczech, na terenie landu Meklemburgia, odnotowano ognisko zakażeń enterokrwotocznymi bakteriami Escherichia coli (EHEC). Według oficjalnego komunikatu z 28 sierpnia 2025 r. potwierdzono laboratoryjnie 12 przypadków tych zakażeń. Doniesienia medialne sugerują jednak, że łączna liczba zgłoszonych zachorowań (wliczając niepotwierdzone jeszcze przypadki) może przekraczać 20. Większość chorych stanowią dzieci i młodzież w wieku od 1 do 15 lat, choć zakażenia odnotowano również u kilku osób dorosłych.
Poważny przebieg choroby obserwuje się u części najmłodszych pacjentów. U pięciorga dzieci rozwinął się zespół hemolityczno-mocznicowy (HUS) – groźne powikłanie infekcji prowadzące do ostrej niewydolności nerek. Około ośmiu osób wymaga hospitalizacji, przy czym cztery dzieci są w ciężkim stanie i przebywają na oddziałach intensywnej terapii.
Powiat Vorpommern-Rügen: Według danych służb sanitarno-epidemiologicznych w tym nadmorskim regionie stwierdzono 7 potwierdzonych przypadków zakażenia EHEC, z czego 5 osób wymagało leczenia szpitalnego. U trojga dzieci spośród chorych z powiatu Vorpommern-Rügen rozwinęło się HUS, a dwoje dzieci jest w stanie na tyle poważnym, że przebywa na intensywnej terapii. Zdecydowana większość osób dotkniętych zakażeniem to turyści przebywający na wakacjach w regionie; jedynie dwie zakażone osoby są mieszkańcami Meklemburgii. Według niektórych źródeł medialnych faktyczna liczba chorych w tym powiecie mogła być wyższa – informowano nawet o 10 przypadkach (w tym 6 turystów oraz 4 osoby miejscowe). Rozbieżności te wynikają prawdopodobnie z wliczania do statystyk przypadków podejrzewanych, które nie zostały jeszcze potwierdzone laboratoryjnie.
Powiat Vorpommern-Greifswald: Oficjalnie potwierdzono tam 5 zachorowań – dotyczyły one czterech małych dzieci (w wieku od 1 do 5 lat) oraz jednej osoby dorosłej. Hospitalizacji wymagało troje dzieci, z czego dwoje leczonych jest na oddziałach intensywnej opieki medycznej. Pojawiły się również informacje o dodatkowym podejrzeniu zakażenia w tym powiecie, co dawałoby łączną liczbę do 6–7 chorych w Vorpommern-Greifswald (uwzględniając niepotwierdzone przypadki). Dwoje dzieci z tego powiatu doznało powikłań w postaci HUS; według dostępnych danych jedno z nich wciąż przebywa na intensywnej terapii.
Działania służb i dochodzenie epidemiologiczne
Władze sanitarne prowadzą intensywne dochodzenie, analizując wszystkie możliwe drogi przenoszenia EHEC. Zlecono rozszerzone badania próbek kału w celu porównania szczepów i ustalenia powiązań między przypadkami. Równolegle prowadzone są wywiady z rodzicami chorych dzieci dotyczące diety i kontaktu ze zwierzętami. Kontrolowane są także łańcuchy dostaw żywności, a pierwsze próbki badane w LALLF okazały się negatywne. Źródło zakażenia pozostaje nieustalone.
Charakterystyka zakażeń EHEC i powikłania HUS
Szczególną uwagę zwraca fakt, że w obecnym ognisku odsetek przypadków z powikłaniami w postaci HUS jest wyraźnie podwyższony w stosunku do typowej sytuacji epidemiologicznej w regionie, gdzie rejestruje się zwykle pojedyncze zachorowania rocznie. Wysoka liczba ciężkich przebiegów w krótkim czasie stanowi istotny sygnał dla służb zdrowia publicznego oraz laboratoriów diagnostycznych, które monitorują dalszy rozwój sytuacji i poszukują źródła zakażeń.
Przeczytaj także
-
 05.09.2025
05.09.2025
Belgia w 2024 roku: więcej ognisk, więcej zachorowań – wnioski z raportu FASFC
Czytaj więcej -
 01.09.2025
01.09.2025
Rosnąca liczba zakażeń Salmonella Enteritidis w Holandii
Czytaj więcej -
 25.08.2025
25.08.2025
Botulizm we Francji: ostatnie ogniska i dane epidemiologiczne z lat 2018–2024
Czytaj więcej

.png)
.png)
